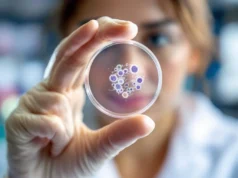
Lymphome : Le cancer du système immunitaire à ne pas négliger

[Vidéo] Les Effets Du Tabagisme Sur Les Poumons
Les Effets Du Tabagisme Sur Les Poumons
https://www.youtube.com/watch?v=5iu6-VKmKGM
#shorts
( 🎥credit: @exemple)
[Vidéo] Sa Tête A Gonflé Après Sa Greffe De Cheveux
Sa Tête A Gonflé Après Sa Greffe De Cheveux
https://www.youtube.com/watch?v=VVe-peL6NUc
#shorts
( 🎥credit: @exemple)
Quels Aliments sont responsables du cancer du foie : découvrez la liste à éviter
Une étude identifie les aliments très spécifiques comme principaux responsables des cancers du foie
Le foie, organe essentiel du métabolisme, possède une capacité d’adaptation face...
Grippe 2026 : une épidémie record qui menace toute la France
Une épidémie de grippe en janvier 2026
En ce début d’année 2026, la France connaît une forte progression de l’épidémie de grippe saisonnière. Selon le...
Comment brûler la graisse viscérale et protéger votre santé
Malgré une alimentation équilibrée et une activité physique régulière, il peut sembler impossible de faire disparaître un ventre épais et dur. La cause principale...
Ne négligez pas ce minéral crucial pour préserver votre mémoire après 50 ans
Après 50 ans, négliger ce minéral pourrait fragiliser votre mémoire plus vite que vous ne le croyez
En début d’année, il est courant de faire...
Grève historique des médecins : crise ou révolution en vue
Une grève nationale des médecins en début de semaine
Ce lundi, les médecins de ville et des cliniques privées entament un mouvement de grève qui...
Marchez vite pour protéger votre cœur
Marche rapide ou modérée : un bénéfice pour le cœur
Une nouvelle étude publiée dans la revue Heart indique que la vitesse à laquelle on...
Lymphome : Le cancer du système immunitaire à ne pas négliger
Un lymphome est un type de cancer qui affecte le sang et le système lymphatique, celui-ci jouant un rôle clé dans le système immunitaire.
Qu'est-ce...
Ne mangez surtout pas la neige, cette habitude peut vous tuer
Pourquoi il ne faut surtout pas manger de la neige
Avec l'arrivée de la neige dans certaines régions de France, beaucoup se demandent si l'on...
![[Vidéo] Les Effets Du Tabagisme Sur Les Poumons Les Effets Du Tabagisme Sur Les Poumons](https://news-sante.fr/wp-content/uploads/2026/01/yt-5iu6-VKmKGM-238x178.jpg)
![[Vidéo] Sa Tête A Gonflé Après Sa Greffe De Cheveux Sa Tête A Gonflé Après Sa Greffe De Cheveux](https://news-sante.fr/wp-content/uploads/2026/01/yt-VVe-peL6NUc-238x178.jpg)